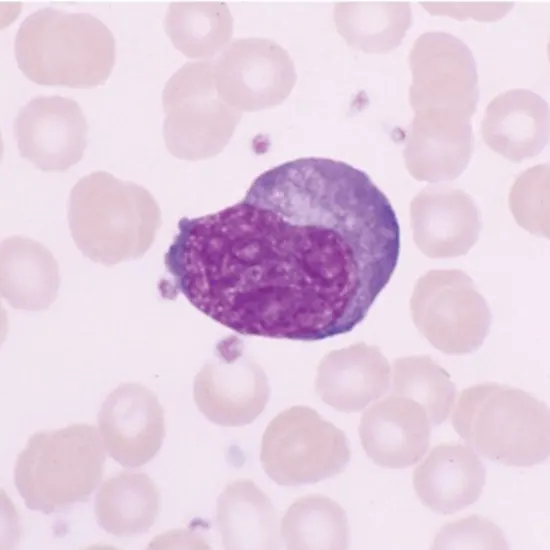
Ehrlichiosis

Book Ehrlichiosis Appointment Online Near me at the best price in Delhi/NCR from Ganesh Diagnostic. NABL & NABH Accredited Diagnostic centre and Pathology lab in Delhi offering a wide range of Radiology & Pathology tests. Get Free Ambulance & Free Home Sample collection. 24X7 Hour Open. Call Now at 011-47-444-444 to Book your Ehrlichiosis at 50% Discount.
Ehrlichiosis is a bacterial infection caused by various species of the Ehrlichia bacteria. It is transmitted to humans through the bite of infected ticks, primarily the lone star tick (Amblyomma americanum) in the United States. Ehrlichiosis is most commonly reported in the southeastern and south-central regions of the United States, but cases have also been reported in other parts of the country, as well as in other regions of the world.
Three main types of ehrlichiosis affect humans: human monocytic ehrlichiosis (HME), human granulocytic ehrlichiosis (HGE), and human ewingii ehrlichiosis (HEE).
Symptoms of ehrlichiosis can vary but often include fever, chills, headache, muscle aches, fatigue, and sometimes rash. More severe cases may result in complications such as respiratory distress, renal failure, or central nervous system involvement. Ehrlichiosis can be a serious and potentially life-threatening disease, particularly in individuals with weakened immune systems or other underlying health conditions.
Diagnosis of ehrlichiosis usually involves a combination of clinical evaluation, medical history, and laboratory testing. Blood tests, such as polymerase chain reaction (PCR) or serological tests, may be used to detect the presence of Ehrlichia bacteria or the antibodies produced by the body in response to the infection.
| CBC | 175 | |
| KFT | 400 | |
| C-Reactive Protein | 200 | |
| Peripheral Blood Smear | 100 | |
| Giemsa Stain | 175 | |
| X Ray Chest | 225 | |
| CECT Chest | 3500 | |
| Test Price | 4775 |
| Test Type | Ehrlichiosis |
| Includes | Ehrlichiosis (Common Diseases) |
| Preparation | |
| Reporting | Within 24 hours* |
| Test Price |
₹ 4775
|

Early check ups are always better than delayed ones. Safety, precaution & care is depicted from the several health checkups. Here, we present simple & comprehensive health packages for any kind of testing to ensure the early prescribed treatment to safeguard your health.